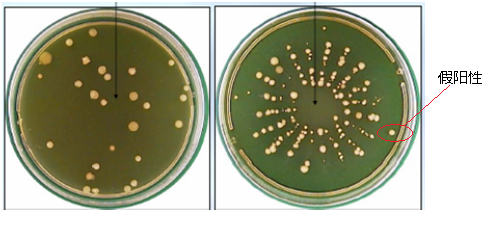
1500951046147645.png image001(03-24-1(07-25-10-41-43).png

浮游菌采樣器孔洞式與狹縫式有何區(qū)別?
1. 浮游菌的采樣原理無論美國Lighthouse品牌空氣浮游菌采樣器還是其他進口品牌都是一致的,都是所謂的安德森撞擊原理,和大家日常洗澡時使用的淋噴頭是一樣的原理,簡單來說就是氣流經(jīng)過小孔加速,帶動浮游菌撞擊到培養(yǎng)皿的瓊脂上,之后拿去培養(yǎng)獲得菌落。所以撞擊頭的設(shè)計就成為了關(guān)鍵,這個孔開大開小,長條形還是圓形甚至五角形都是可以的,孔洞式與狹縫式除了現(xiàn)狀上的區(qū)別,理論上沒有其他區(qū)別,但是他們都必須要通過第三方的實驗室驗證捕獲率,通常捕獲率在90%-110%之間,都算合格的。第三方實驗室得出的捕獲率驗證通過了,這個設(shè)計也就可以被使用了。
PMS的第三方驗證實驗室是CAMR
LWS的第三方驗證實驗室是 PHE
2. 關(guān)于假陽性,實質(zhì)上是一種銷售噱頭,假陽性的對比實驗如下:
通過孔洞式浮游菌采樣結(jié)果 通過狹縫式采樣結(jié)果
從圖片可以看到,假陽性實驗本身是建立在高濃度浮游菌污染的情況下做,只有在這樣的情況下,才會出現(xiàn)(右圖)菌落呈現(xiàn)放射狀排列,凡是不在放射狀菌落范圍內(nèi)的菌落,可稱之為假陽性數(shù)據(jù)。而普通的孔洞式由于沒有一個圖形范圍,所以就區(qū)分不出是否假陽性。這個就是PMS宣傳的所謂排除假陽性實驗。
但是實際上上圖的結(jié)果,以如此高的浮游菌污染結(jié)果,糾結(jié)是否真假陽性,根本就沒有意義了。
在實際的操作中,只要出現(xiàn)1個菌落,基本就判定不合格了,只要有1個菌落的出現(xiàn),無論是孔洞還是狹縫,都不存在假陽性的結(jié)果,結(jié)果都是不合格。
所以假陽性本身就是一個不存在悖論,或者無需關(guān)注的現(xiàn)象,浮游菌要關(guān)注的就是有 或者 沒有。